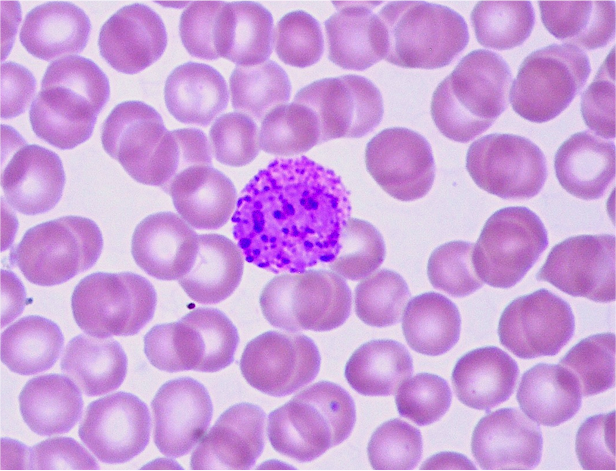

I Never Thought a Simple Urine Test Could Tell So Much” — What I Learned About Leukocytes in Urine
A few months ago, I went for a routine health check-up. Nothing special — just the usual tests. But when the report came back, one small word caught my attention: leukocytes. I didn’t even know what it meant. My doctor explained that it’s another term for white blood cells, and their presence in urine could mean an infection. That little line on the report sent me down a rabbit hole of research and personal reflection on how our bodies send signals we often ignore.
What Leukocytes Really Mean
Leukocytes are your immune system’s soldiers. They show up to fight infections, and when they appear in urine, it’s often because your urinary tract or kidneys are under attack. According to a detailed article from AskDocDoc (https://askdocdoc.com/articles/1068-leukocytes-in-urine-everything-you-need-to-know
), common reasons include urinary tract infections (UTIs), kidney inflammation, or even a blockage from stones. Sometimes, though, they appear because of something as simple as sample contamination or dehydration.
The science makes sense — but what stood out to me were the small habits that make a huge difference. For example, I came across a short post on Threads (https://www.threads.com/@askdocdoc/post/DPwPGtrjgPt
) explaining how most people don’t notice early UTI symptoms until the infection becomes painful. It made me realize how often we brush off minor discomforts.
What I Found in the Community
When I looked deeper, I found even more valuable insights shared by everyday people and health experts online.
A post on X (https://x.com/1881713393369030656/status/1977751452597592147
) talked about how holding your pee for too long can encourage bacteria to multiply — something I’m definitely guilty of during long workdays. Meanwhile, a professional discussion on LinkedIn (https://www.linkedin.com/feed/update/urn:li:share:7383517254744936448
) stressed how untreated kidney infections can escalate to sepsis, a serious condition that I never knew could start from something as small as a UTI.
Then I stumbled upon a Pinterest post (https://www.pinterest.com/pin/928445279439396405
) showing a list of foods that support urinary health — cranberries, yogurt, and green vegetables. Simple, everyday stuff. And on Facebook (https://www.facebook.com/122099392514743210/posts/122143353596743210
), a few people shared personal stories about noticing leukocytes early and getting treatment before things got worse. It was comforting to see others taking these small signs seriously.
Lessons That Stuck With Me
Hydration really matters. Water flushes out bacteria, keeps your urine clear, and supports kidney function.
Listen to discomfort. Pain, burning, or cloudy urine isn’t “normal.” It’s your body asking for help.
Get checked early. A simple urine test can catch an infection before it spreads.
Take prevention seriously. Hygiene habits and diet choices make more difference than we think.
Learning about leukocytes in urine wasn’t just about understanding a lab term — it was a reminder to slow down and listen to my body.
What About You?
Have you ever had a small test result turn into a learning moment about your health? How do you balance between not worrying too much and taking your body’s signals seriously? I’d love to hear your thoughts and stories in the comments.